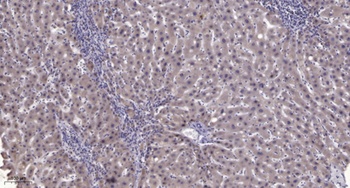
PC-PLD1 (phospho Thr147) rabbit pAb Antibody

You have no items in your shopping cart.
Search results for: 'phospho antibody'
- Featured
Stat6 (phospho Thr645) rabbit pAb Antibody [orb764283]Featured
ELISA, IF, IHC, IP, WB
Human, Mouse, Rat
Polyclonal
Unconjugated
100 μl, 50 μl - Featured
Tau (phospho Ser235) rabbit pAb Antibody [orb764286]Featured
ELISA, WB
Human, Mouse, Rat
Polyclonal
Unconjugated
100 μl, 50 μl - Featured
Tau (phospho Ser404) rabbit pAb Antibody [orb764288]Featured
ELISA, WB
Human, Mouse, Rat
Polyclonal
Unconjugated
100 μl, 50 μl - Featured
GATA-1 (phospho Ser310) rabbit pAb Antibody [orb764194]Featured
ELISA, WB
Human, Monkey, Mouse, Rat
Polyclonal
Unconjugated
100 μl, 50 μl - Featured
ICAM-1 (phospho Tyr512) rabbit pAb Antibody [orb764208]Featured
ELISA, WB
Human, Mouse, Rat
Polyclonal
Unconjugated
100 μl, 50 μl - Featured
PKD2 (phospho Ser812) rabbit pAb Antibody [orb769472]Featured
ELISA, IHC, WB
Human, Mouse, Rat
Polyclonal
Unconjugated
100 μl, 50 μl - Featured
eNOS (phospho Ser615) rabbit pAb Antibody [orb769275]Featured
ELISA, WB
Human, Mouse, Rat
Polyclonal
Unconjugated
100 μl, 50 μl - Featured
PC-PLD1 (phospho Thr147) rabbit pAb Antibody [orb769486]Featured
ELISA, IHC, WB
Human, Mouse, Rat
Polyclonal
Unconjugated
100 μl, 50 μl - Featured
Raf-1 (phospho Ser642) rabbit pAb Antibody [orb769854]Featured
ELISA, IHC, WB
Human, Mouse, Rat
Polyclonal
Unconjugated
50 μl, 100 μl - Featured
DNA-PKCS (phospho Thr2638) rabbit pAb Antibody [orb769679]Featured
ELISA, IF
Human, Mouse
Polyclonal
Unconjugated
100 μl, 50 μl